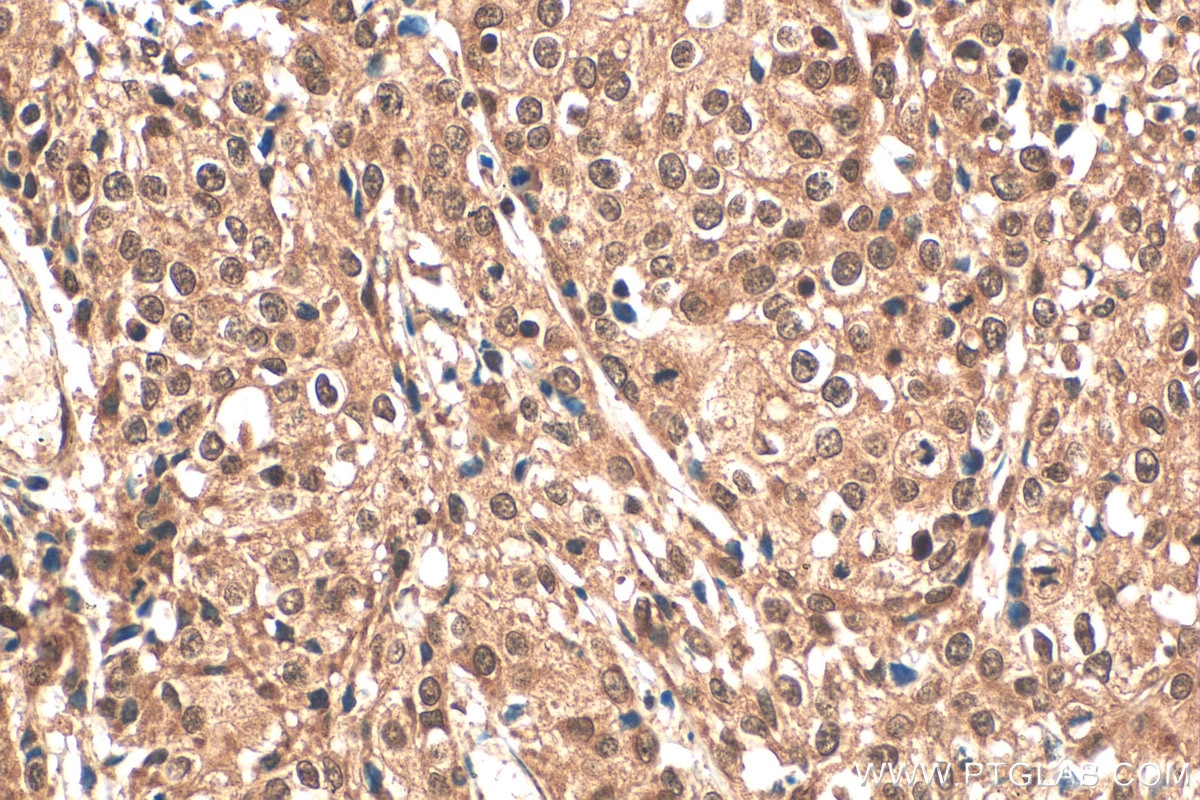
Immunohistochemistry (IHC) staining of human cervical cancer tissue using IRF9 Polyclonal antibody (14167-1-AP)

Validation Data Gallery
Tested Applications
| Positive WB detected in | A549 cells, mouse heart tissue, rat heart tissue, HepG2 cells, MCF-7 cells, HeLa cells, THP-1 cells |
| Positive IP detected in | mouse heart tissue |
| Positive IHC detected in | human cervical cancer tissue Note: suggested antigen retrieval with TE buffer pH 9.0; (*) Alternatively, antigen retrieval may be performed with citrate buffer pH 6.0 |
| Positive IF/ICC detected in | HepG2 cells |
Recommended dilution
| Application | Dilution |
|---|---|
| Western Blot (WB) | WB : 1:1000-1:6000 |
| Immunoprecipitation (IP) | IP : 0.5-4.0 ug for 1.0-3.0 mg of total protein lysate |
| Immunohistochemistry (IHC) | IHC : 1:50-1:500 |
| Immunofluorescence (IF)/ICC | IF/ICC : 1:20-1:200 |
| It is recommended that this reagent should be titrated in each testing system to obtain optimal results. | |
| Sample-dependent, Check data in validation data gallery. | |
Published Applications
| KD/KO | See 4 publications below |
| WB | See 38 publications below |
| IHC | See 8 publications below |
| IF | See 6 publications below |
| IP | See 1 publications below |
| ChIP | See 3 publications below |
Product Information
14167-1-AP targets IRF9 in WB, IHC, IF/ICC, IP, ChIP, ELISA applications and shows reactivity with human, mouse, rat samples.
| Tested Reactivity | human, mouse, rat |
| Cited Reactivity | human, mouse, rat, pig, canine, sheep |
| Host / Isotype | Rabbit / IgG |
| Class | Polyclonal |
| Type | Antibody |
| Immunogen |
CatNo: Ag5365 Product name: Recombinant human IRF9 protein Source: e coli.-derived, PGEX-4T Tag: GST Domain: 1-393 aa of BC035716 Sequence: MASGRARCTRKLRNWVVEQVESGQFPGVCWDDTAKTMFRIPWKHAGKQDFREDQDAAFFKAWAIFKGKYKEGDTGGPAVWKTRLRCALNKSSEFKEVPERGRMDVAEPYKVYQLLPPGIVSGQPGTQKVPSKRQHSSVSSERKEEEDAMQNCTLSPSVLQDSLNNEEEGASGGAVHSDIGSSSSSSSPEPQEVTDTTEAPFQGDQRSLEFLLPPEPDYSLLLTFIYNGRVVGEAQVQSLDCRLVAEPSGSESSMEQVLFPKPGPLEPTQRLLSQLERGILVASNPRGLFVQRLCPIPISWNAPQAPPGPGPHLLPSNECVELFRTAYFCRDLVRYFQGLGPPPKFQVTLNFWEESHGSSHTPQNLITVKMEQAFARYLLEQTPEQQAAILSLV 相同性解析による交差性が予測される生物種 |
| Full Name | IRF 9 |
| Calculated molecular weight | 393 aa, 44 kDa |
| Observed molecular weight | 44-48 kDa |
| GenBank accession number | BC035716 |
| Gene Symbol | IRF9 |
| Gene ID (NCBI) | 10379 |
| RRID | AB_2296227 |
| Conjugate | Unconjugated |
| Form | |
| Form | Liquid |
| Purification Method | Antigen affinity purification |
| UNIPROT ID | Q00978 |
| Storage Buffer | PBS with 0.02% sodium azide and 50% glycerol{{ptg:BufferTemp}}7.3 |
| Storage Conditions | Store at -20°C. Stable for one year after shipment. Aliquoting is unnecessary for -20oC storage. |
Background Information
IRF9 also named ISGF3 is a transcription regulatory factor that mediates signaling by type I IFNs (IFN-alpha and IFN-beta). Following type I IFN binding to cell surface receptors, Jak kinases (TYK2 and JAK1) are activated, leading to tyrosine phosphorylation of STAT1 and STAT2. The phosphorylated STATs dimerize, associate with IRF9/ISGF3G to form a complex termed ISGF3 transcription factor, that enters the nucleus. ISGF3 binds to the IFN stimulated response element (ISRE) to activate the transcription of IFN stimulated genes, which drive the cell in an antiviral state.
Protocols
| Product Specific Protocols | |
|---|---|
| IF protocol for IRF9 antibody 14167-1-AP | Download protocol |
| IHC protocol for IRF9 antibody 14167-1-AP | Download protocol |
| IP protocol for IRF9 antibody 14167-1-AP | Download protocol |
| WB protocol for IRF9 antibody 14167-1-AP | Download protocol |
| Standard Protocols | |
|---|---|
| Click here to view our Standard Protocols |
Publications
| Species | Application | Title |
|---|---|---|
Cell Rep miR-342-5p decreases ankyrin G levels in Alzheimer's disease transgenic mouse models. | ||
PLoS Pathog A host cell long noncoding RNA NR_033736 regulates type I interferon-mediated gene transcription and modulates intestinal epithelial anti-Cryptosporidium defense. | ||
Mol Cancer Ther JAK2 inhibitor SAR302503 abrogates PD-L1 expression and targets therapy resistant non-small cell lung cancers. | ||
J Immunol Herpes Simplex Virus Type 2 Inhibits Type I IFN Signaling Mediated by the Novel E3 Ubiquitin Protein Ligase Activity of Viral Protein ICP22. |